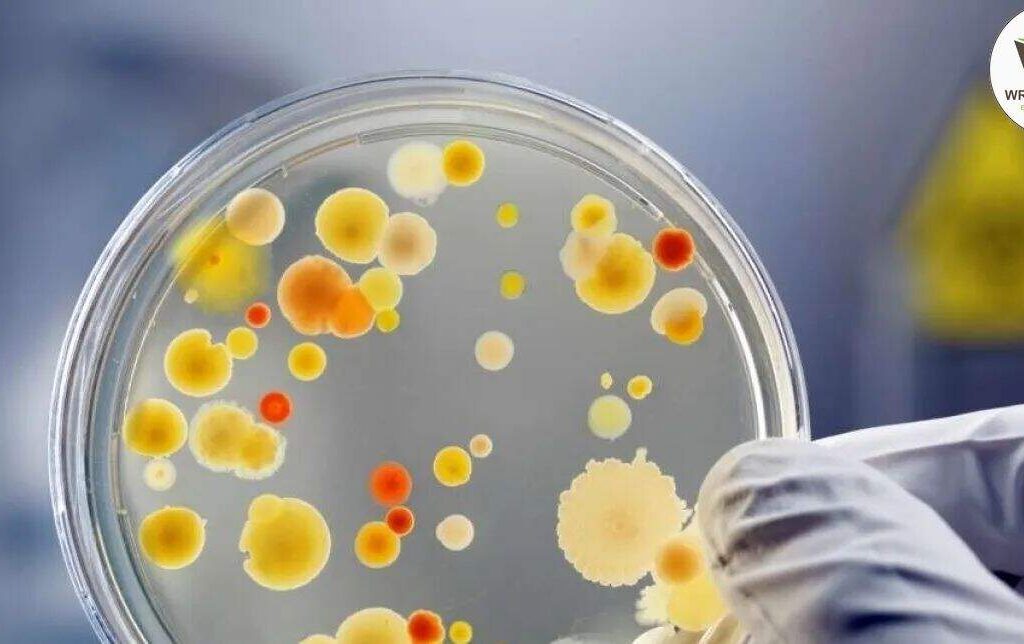

Institucional
SCROLL
Exibindo 369–384 de 471 resultados

Curso Melhorias na Administração em Enfermagem
R$80 Quick ViewComprarCurso Melhorias na Administração em Enfermagem
R$80

Curso Metodologia da Pesquisa Científica
R$80 Quick ViewComprarCurso Metodologia da Pesquisa Científica
R$80

Curso Metodologia do Ensino da Geografia
R$80 Quick ViewComprarCurso Metodologia do Ensino da Geografia
R$80

Curso Microbiologia Ambiental
R$80 Quick ViewComprarCurso Microbiologia Ambiental
R$80

Curso Microbiologia e Imunologia
R$80 Quick ViewComprarCurso Microbiologia e Imunologia
R$80

Curso Mídias Digitais na Educação Matemática
R$80 Quick ViewComprarCurso Mídias Digitais na Educação Matemática
R$80

Curso Ministério dos Diáconos
R$80 Quick ViewComprarCurso Ministério dos Diáconos
R$80

Curso Modelagem de Informação da Construção
R$80 Quick ViewComprarCurso Modelagem de Informação da Construção
R$80

Curso Naturoterapia
R$80 Quick ViewComprarCurso Naturoterapia
R$80

Curso Neurolinguística Aplicada ao Ensino e Aprendizagem
R$80 Quick ViewComprarCurso Neurolinguística Aplicada ao Ensino e Aprendizagem
R$80

Curso Neurologia para Cães e Gatos
R$80 Quick ViewComprarCurso Neurologia para Cães e Gatos
R$80